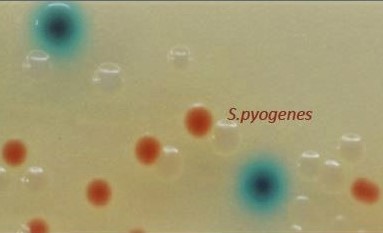
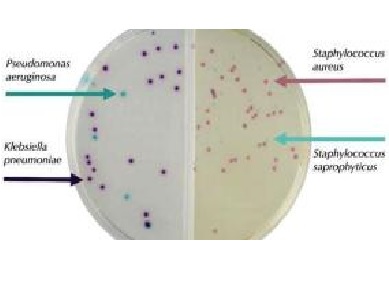

Virus Transport Medium (GLYE)
Το Virus Transport Medium (GLYE) χρησιμοποιείται ως συντηρητικό υλικό για τη διατήρηση της βιωσιμότητας των ιών από τον τόπο συλλογής στο εργαστήριο δοκιμών. Το σωληνάριο είναι πλαστικό με βιδωτό πώμα (PP ø12,5x85mm- 9ml max, temp. 123 έως -85 °C) και περιέχει γυάλινα σφαιρίδια για καλύτερη διάχυση του δείγματος κατά την ανάδευση.
Virus Transport Medium (GLYE) Read More »
Νέα, Νέα Προϊόντα